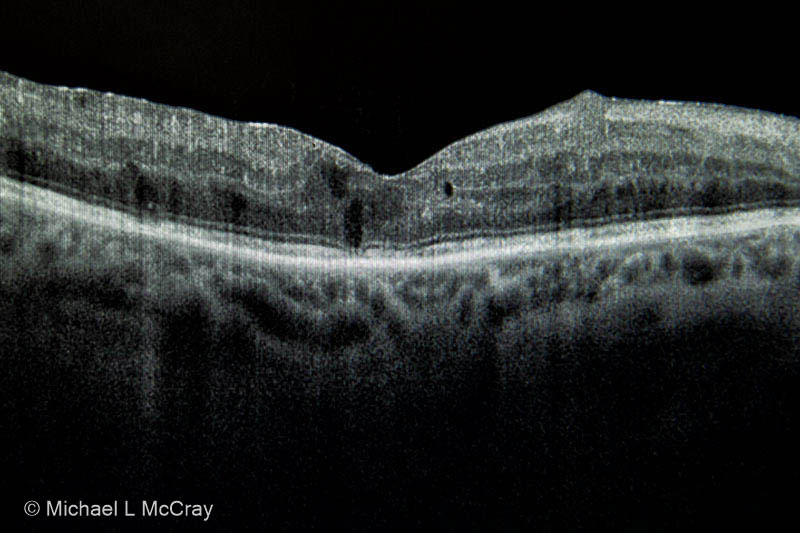

After my military service in the United States Army, which was served in the DMZ of Korea, I attended Cuyahoga County Community College becoming an Emergency Medical Technician. Decided to continue my education at Southern Utah State College majoring in biology and chemistry. Then attended Kent State University School of Journalism for photo-illustration.
The thing you learn about war is it is a medical event. Homelessness is also one of byproducts for some of every group involved.
I have primarily earned my living as an ophthalmic photographer. However, I have worked as a photojournalist for daily & weekly newspapers and freelanced covering conflicts in Afghanistan and Central America in the 80’s. I focused on the social and medical issue in conflicts and was able to generate support from the medical community here and overseas.
My knowledge of pathology landed me a position as Community Outreach Coordinator for Cleveland Eye Clinic. I led a team which screened over 45,000 people in NE Ohio communities for vision problems which received national recognition. In the evenings I provided vision screenings for Health Care for the Homeless’ outreach in Cleveland for a number of years.
It was during this time that I started Iris Imaging to provide services to the eye care community of NE Ohio.